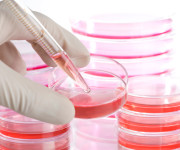
METODO STAMINA

Aderiamo alla manifestazione che si terrà domani 25 novembre alle ore 10.00 a piazza Montecitorio in Roma.
Aderiamo alla manifestazione che si terrà domani 25 novembre alle ore 10.00 a piazza Montecitorio in Roma.
“Il diritto alla cura è sancito dall’art. 32 della Costituzione Italiana, tuttavia, a causa di tagli alle spese inaccettabili e con una classe politica dirigente sempre più latitante nei confronti dei propri doveri verso i cittadini, tale diritto è di fatto negato anche e soprattutto a chi è affetto da gravi patologie che, a quanto pare, non sembrerebbero soddisfare le esigenze di profitto delle grandi lobbies internazionali”, così dichiara Valeria Campana, dirigente di Primavera Nazionale, nell’annunciare l’adesione del movimento alla protesta che i fratelli Marco e Sandro Biviano dal 23 luglio portano avanti per mezzo di un presidio fisso a piazza Montecitorio in Roma.
“In linea con i principi di difesa delle famiglie, di giustizia sociale e a tutela di chi non può accedere a cure costose tutt’ora erogate all’estero, ci schieriamo a fianco dei malati di patologie degenerative gravi ai quali è stata negata la speranza concreta delle cure basate su cellule staminali mesenchemiali, che a tutt’oggi, nei casi clinici osservati, hanno dato risultati concreti e riconosciuti da eminenti esponenti della comunità scientifica, oltre che miglioramenti clinici oramai inconfutabili”, conclude la nota.



